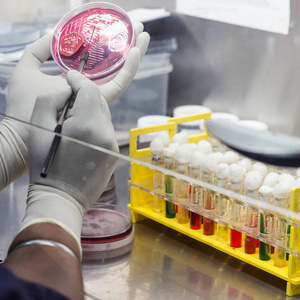
微生物实验室油烟机内的科学家接种环培养板上的 mac 麦康开琼琼脂

麦康肠内营养泵

肠内营养泵
图片尺寸417x431
肠内营养泵 鼻饲泵肠内营养输注泵营养泵 麦康np09肠内营养泵*1台
图片尺寸800x800
肠内喂养泵
图片尺寸800x1131
肠内营养泵
图片尺寸500x279
肠内营养泵np09
图片尺寸310x327
医用肠内营养泵 输液泵 营养输入泵
图片尺寸310x310
肠内营养泵 hk-300
图片尺寸750x750
肠内营养泵
图片尺寸646x800
肠内营养泵sk700i
图片尺寸400x400
肠内营养泵
图片尺寸132x215
肠内营养泵 sk-700i品牌:深科 型号:sk-700i价格:签约议价肠内营养
图片尺寸400x400
肠内营养泵鼻饲泵肠内营养液输送泵家用老人成人儿童自制流食电动液晶
图片尺寸790x1218肠内营养泵使用方法
图片尺寸640x478
便携式医疗设备肠内营养泵rs232接口
图片尺寸680x452
en7s肠内营养泵_康爱超市 - 易加医
图片尺寸1592x1594
hk-300 肠内营养泵
图片尺寸731x603
肠内营养泵-善德仕医疗科技(北京)有限公司
图片尺寸600x400
sk-700i 肠内营养泵 连续式匀速喂养 无线监护功能 报警系统
图片尺寸700x700
麦康 肠内营养袋家用鼻饲喂食袋一次性肠内营养液供应管路重力型泵型
图片尺寸800x800
微生物实验室油烟机内的科学家接种环培养板上的 mac 麦康开琼琼脂
图片尺寸300x300
猜你喜欢:佰通肠内营养泵肠内营养泵好克肠内营养泵肠内营养泵品牌肠内营养输注泵英复特肠内营养泵肠内营养泵图片复尔凯肠内营养泵肠内营养鼻饲泵复尔凯肠内营养泵管肠内营养制剂纽迪希亚肠内营养泵肠内营养泵的使用图解肠内营养管肠内营养肠内营养剂肠内营养剂安素肠内营养乳剂肠内营养混悬液安素肠内营养粉肠内营养粉剂瑞代肠内营养乳剂瑞高肠内营养乳剂肠内营养液肠内营养图片瑞能肠内营养乳剂短肽型肠内营养剂肠内营养卡通肠内营养泵使用流程图肠内营养乳剂说明书丁真照片高清帅气巨蟹座拟人男成都十大必吃美食图片小猪佩奇正面图瓜子脸是什么样子的心灰意冷的句子 失望白音华煤矿凤尾草能治妇科炎症吗竖缝式鱼道邵群程秀各种车欧洲骑士大剑cici一年级